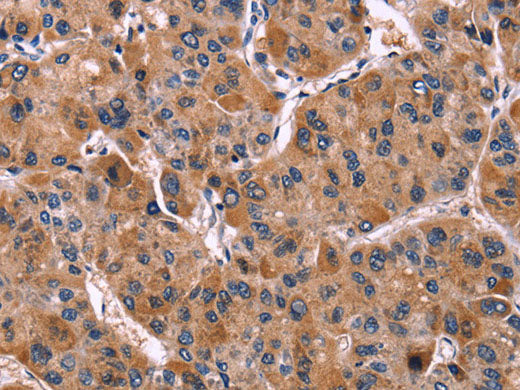
LILRB1 Polyclonal Antibody
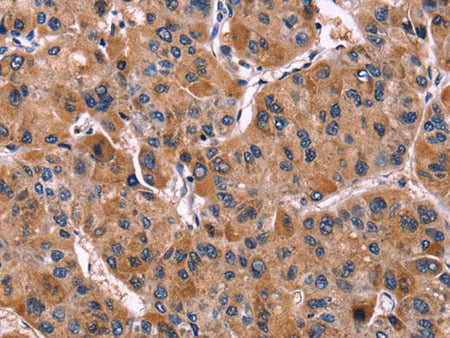
LILRB1 Polyclonal Antibody

LILRB1 Polyclonal Antibody
Couldn't load pickup availability

Still have questions? Ask our experts!
LILRB1 Polyclonal Antibody
| SKU # | E-AB-10412 |
| Reactivity | Human |
| Host | Rabbit |
| Applications | IHC |
Product Details
| Isotype | IgG |
| Host | Rabbit |
| Reactivity | Human |
| Applications | IHC |
| Clonality | Polyclonal |
| Immunogen | Recombinant protein of human LILRB1 |
| Abbre | LILRB1 |
| Synonyms | CD85, CD85 antigen, CD85 antigen like family member J, CD85 antigen-like family member J, CD85j, CD85j antigen, ILT 2, ILT-2, ILT2, Ig like transcript 2, Immunoglobulin-like transcript 2, Leukocyte immuno, immunoglobulin like transcript 2, leukocyte Ig like receptor 1 |
| Swissprot | |
| Cellular Localization | Membrane. |
| Concentration | 0.3 mg/mL |
| Buffer | Phosphate buffered solution, pH 7.4, containing 0.05% stabilizer and 50% glycerol. |
| Purification Method | Affinity purification |
| Research Areas | Immunology |
| Conjugation | Unconjugated |
| Storage | Store at -20°C Valid for 12 months. Avoid freeze / thaw cycles. |
| Shipping | The product is shipped with ice pack,upon receipt,store it immediately at the temperature recommended. |
Related Reagents
| Applications | Recommended Dilution |
| IHC | 1:50-1:200 |
Background
This gene is a member of the leukocyte immunoglobulin-like receptor (LIR) family, which is found in a gene cluster at chromosomal region 19q13.4. The encoded protein belongs to the subfamily B class of LIR receptors which contain two or four extracellular immunoglobulin domains, a transmembrane domain, and two to four cytoplasmic immunoreceptor tyrosine-based inhibitory motifs (ITIMs). The receptor is expressed on immune cells where it binds to MHC class I molecules on antigen-presenting cells and transduces a negative signal that inhibits stimulation of an immune response. It is thought to control inflammatory responses and cytotoxicity to help focus the immune response and limit autoreactivity. Multiple transcript variants encoding different isoforms have been found for this gene.
.